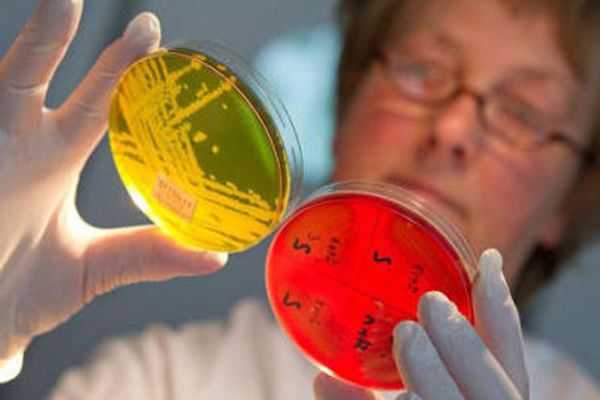

Стафилококк в носу: причины, симптомы и что делать
Стафилококк – это условно — патогенная бактерия, которая в ряде случаев является частью микробиоценоза человека. При определенном состоянии организма человека, стафилококк может проявлять свою активность, особенно при ослабленном иммунитете, а также при создании благоприятной обстановки для его прогрессирования. В частности, в случае перенесения тяжелого заболевания, стафилококк может быть вторичной инфекцией, приобретенной вследствие снижения иммунитета от первичной болезни.
Стафилококковая инфекция в носу – это заболевание, которое характеризуется размножением в носоглотке стафилококковых бактерий и несет за собой симптомы поражения носа и гортани. Эта инфекция очень коварна и устойчива к медикаментам, даже к антибиотикам.
Формы
На сегодняшний день, выделяют несколько форм стафилококковой инфекции, самые распространенные из них это:
- Сапрофитовая – эта форма, считается наиболее легкой, в основном развивается в мочеполовой системе, может провоцировать такую болезнь, как цистит.
- Эпидермальная – данный вид является обитателем кожи человека и слизистых оболочек. При определенных условиях кокки начинают размножаться и проникают в кровь, становясь причиной развития воспалительных процессов в глубоких слоях кожи.
- Золотистая – наиболее тяжелый вид инфекции, может вызывать более 100 видов болезней, чаще всего развивается в желудочно-кишечном тракте и носовой полости, очень устойчив к лечению.
Причины и пути заражения
К основным путям заражения относятся: бытовой, пищевой, воздушно-капельный, от матери к ребенку. К большому огорчению, заразиться чаще всего стафилококком можно при посещении больниц и других мед. учреждений. Плохо стерилизованные медицинские инструменты, грязные руки, не поменянные перчатки после осмотра другого пациента, все это может сопутствовать заражению этим заболеванием. Также, не соблюдение правил личной гигиены дома.
Развитию бактерий в носу сопутствует сухой, мало проветренный воздух внутри помещения. Часто встречаются больные данным видом инфекции, которые имеют ослабленный иммунитет на фоне перенесенных других тяжелых заболеваний, при дисбактериозе кишечника или злоупотреблении антибиотикотерапией.
Это заболевание очень распространено среди младенцев, также деток, которые ходят в государственные дошкольные учреждения. Поскольку чаще всего, в этих местах не соблюдаются нормы по проветриванию, кварцеванию и влажной уборке помещения.
Длительное использование сосудосуживающих капель от насморка, может привести к риниту, вызванному избытком применения медикаментов. На фоне этого состояния, бактериям очень легко развиваться в носовом ходе.
Можно с уверенностью сказать, что даже сильный стресс и переутомление, может спровоцировать развитие стафилококка.
Симптоматика
Находясь на слизистой оболочке носа и ротоглотки, кокки могут провоцировать к прогрессированию заболевания верхних дыхательных путей. Для разграничения банального ОРЗ, вируса или все-таки какого-то из видов стафилококка, больному необходимо пройти незамедлительно обследование.
Поскольку лечение у всех болезней разное и не всегда антибиотики могут помочь, но и навредить, вызвав дисбактериоз кишечника с установлением диагноза затягивать нельзя.
К наиболее частым симптомам стафилококка в носу и горле относят:
- Покраснение слизистой оболочки горла.
- Длительная заложенность носа, затрудненное носовое дыхание.
- Возможно повышение температуры тела.
- Образование корочек в носовой полости, похожих на засохший герпес.
- В более серьезных формах – гнойные высыпания на слизистой носа и ротоглотки.
- Устойчивость к медикаментозному лечению насморка.
- Общая интоксикация организма.
Диагностика
При наличии симптомов, описанных выше, нужно безотлагательно обратиться к врачу для диагностики заболевания и определения схемы лечения.
Главным методом диагностики стафилококка в носу является бактериологическое исследование, которое проводится путем взятие мазка из носа и зева. Для определения наличия или отсутствия заболевания, его формы, очень важно правильно сделать забор материала.
Первое условия для проведения правильного анализа — это подготовка:
- За день до сдачи бактериального посева необходимо отказаться от применения любых препаратов от насморка, даже от обычных солевых растворов.
- Для получения правильной картины болезни, минимум за 7 дней не использовать в лечении антибиотики.
Только один минус присущ этому методу, который заключается в том, что результат посева придется ждать примерно 7 дней.
Существуют и другие исследования, которые проводятся более быстро – микроскопический способ анализа мазка, но в отличие от бакпосева, он не выявляет конкретную форму бактерии, и не дополняет сведения антибиотикограммой, что очень необходимо при назначении антибиотикотерапии.
Если бактерии стафилококка будут выявлены у одного члена семьи, то анализ придется сдать всем домочадцам и лечение проходить тоже.
Лечение
Одним из самых применяемых методов лечения инфекции стафилококка является антибиотикотерапия. Схема лечения и сам препарат подбирается индивидуально с помощью антибиотикограммы.
Всегда, при выявлении инфекции в носу, инфицированному назначают препараты не только наружного применение, но и внутрь в виде таблеток или даже инъекций, а также антигистаминные препараты.
Возможно несколько вариантов лечения, рассмотрим каждый из них:
- Применение антибактериальных препаратов, которые оказывают воздействие на организм человека и его иммунитет. Наиболее распространенные – это «Цефтриаксон», «Офлоксацин», «Азитромицин». Пенициллиновый ряд антибиотиков не применяют, поскольку кокки очень стойки к нему.
- Локальное использование антибактериальных препаратов – мазей, в состав которых входит мупироцин. Указанные средства применяются в носовых ходах, в основном, 2 раза в сутки на протяжении 7 дней. Научно доказано, что при использовании гелей в носу, кокки исчезают по всей протяженности рота и носоглотки.
- Что касается последнего варианта лечения – это применение «Стафилококкового бактериофага». Данный метод находится в процессе изучения, но уже широко применяется в терапии, как альтернатива антибиотикам.
Кроме указанной выше терапии, обязательным является применение:
- Иммуно-модулируищих препаратов («Циклоферон», «Иммунал», «Иммунофлазид» и др.)
- Антигистаминных препаратов («Фенистил», «Эдем», «Цетрин») предотвращающих отек слизистых тканей.
- Витаминных препаратов.
- Препаратов местной обработки для улучшения терапевтического эффекта.
Очень хорошее антисептическое действие оказывает «Хлоргексидин», его используют для промывания носа. В качестве сосудосуживающих препаратов назначают «Протаргол», «Изофра», они оказывают антибактериальное действие, очень хорошо помогают при заложенности носа.
Для увлажнения и смазки полости носа и горла используют «Хлорофиллипт», «Эктерицид», они оказывают маслянистый эффект. Если на коже присутствуют гнойничковые поражения и корочки отлично подходит «Тетрациклиновая мазь».
В случае выявления стафилококковой инфекции только в носу, для предотвращения развития болезни в ротовой полости назначают полоскания содой, а также с использованием «Фурацилина».
Последствия стафилококка
Самыми распространенными последствиями инфицирования стафилококком являются гнойные высыпания, пищевые отравления, поражения слизистых оболочек. При несвоевременном лечении, стафилококковая инфекция может поражать внутренние органы и даже привести к заражению крови. Поэтому можно сделать вывод, при выявлении этого заболевание незамедлительно нужно начинать лечение.
Профилактика заболевания
Главным способом предупреждения любой болезни, не только стафилококка – это укрепление организма. Если отказаться от вредных привычек, придерживаться правильного режима отдыха, здорового питания, проводить много времени на свежем воздухе и во время обращаться к врачу, то многие болезни можно предотвратить.
Больше всего стафилококковой инфекции подвержены новорождённые, беременные, пожилые люди и даже молодежь с ослабленным иммунитетом.
Этой категории людей нужна особенная профилактика:
- При малейшем намеке на насморк – промывать нос раствором морской или поваренной соли.
- Увлажнять помещение с помощью увлажнителя воздуха.
- Соблюдать правила личной гигиены.
- Обязательно проветривать помещение, в котором находитесь, чаще делать влажную уборку.
- Перед кормлением новорожденных, маме, бесспорно, мыть руки и грудь.
- Не злоупотреблять применением капель от насморка и антибиотиков.
- Использовать в стирке средства без ароматизаторов.
- Не скапливать предметы, которые могут собирать пыль (мягкие игрушки).
- Кварцевание помещения.
И напоследок, запомните главное правило: любое заболевание легче предупредить, чем лечить.
Похожие записи:
parazits.ru
Стафилококк в носу: откуда берется, симптомы, лечение
Человека постоянно окружает большое количество микробов. Некоторые из них вызывают опасные заболевания у взрослых и детей. Другие в обычных условиях не доставляют хлопот, но в определенных ситуациях начинают стремительно размножаться и становятся причиной болезни. Таков стафилококк в носу – бактерия, поселяющаяся в верхних дыхательных путях, на коже, в кишечнике.
Стафилококк часто выявляется при микроскопическом исследовании содержимого носоглотки. Как правильно реагировать, если результаты теста показали, что в носу обитают стафилококки?

СодержаниеПоказать
Откуда берется стафилококк в носу – способы заражения
загрузка…
Согласно данным медстатистики стафилококки постоянно живут в носоглотке у 20 % людей. Еще у 60 % микробы можно обнаружить время от времени – это носители бактерий. И только 20 % людей обладают настолько сильным иммунитетом, что их эпидермис и слизистые всегда свободны от этого вездесущего микроорганизма.
Что такое стафилококки? Это шаровидные бактерии, находящиеся в воде, воздухе, почве. Увидеть фото стафилококков можно в любом учебнике по лор-заболеваниям. Изо всех стафилококков опасность для человека представляет только три вида. Самый патогенный из них – стафилококк золотистый (Staphylococcus Aureus).

Стафилококк ауреус в носу часто обнаруживают во время диспансеризаций и медосмотров. Этот микроб выявляют у всех групп населения, включая беременных и детей.
Сам по себе положительный результат анализа не говорит о патологии, так как золотистый и другие стафилококки широко распространены. Решая вопрос, опасно ли носительство стафилококка в носу, нужно обращать внимание, присутствуют ли характерные признаки заболеваний, источником которого может стать данная бактерия.Таким образом, стафилококки в носу – это норма, но они несут потенциальную опасность. В определенных условиях микробы способны стать причиной болезней горла и носа.
Стафилококки – удивительные бактерии. Они не образуют спор – образований, помогающих микроорганизмам выживать в неблагоприятных условиях, но при этом очень живучи. Стафилококк всегда готов внедриться в человеческий организм.

Бактерия выдерживает высушивание, многочасовое облучение прямыми солнечными лучами. Золотистые стафилококки не погибают при кипячении. Более того, они выдерживают температуру 150 градусов на протяжении 10 минут. Микроб выживает в чистом спирте, а помещенный в перекись водорода, начинает активно усваивать кислород и размножаться.
Стафилококк прекрасно себя чувствует в крепких растворах соли, поэтому может жить и размножаться на человеческой коже не боясь пота. Стафилококки поселяются прямо в потовых железах – там, где не выживают другие микроорганизмы.
Заразиться стафилококком можно при дыхании, поедании пищи или при медицинских манипуляциях. Неудивительно, что врачи обнаружили этот микроб у огромного количества людей.
Чем опасна активизация стафилококка?
Активизировавшись, бактерии Staphylococcus быстро размножаются и становятся причиной лор-заболеваний: ринита, синусита, аденоидита, тонзиллита, фронита. Первыми симптомами стафилококковой инфекции носа будет скопление слизи на задней стенке горла, из-за чего больному приходится постоянно отхаркиваться. Появляется резкий запах изо рта.
Острый ринит – воспаление слизистой носа вследствие инфекционных и неинфекционных заболеваний. При рините отмечается рост условно-патогенной микрофлоры, которая приводит к раздражению оболочек. Активизация стафилококка в носу чаще всего объясняется переохлаждением организма.

Острый синусит – воспаление околоносовых пазух. Чаще всего возникает вследствие респираторных заболеваний. Характерные симптомы синусита – заложенность только одной половины носа (при двустороннем синусите закладывает обе половины). Повышается температура тела, появляются головные боли, чувствуется болезненность в области корня носа и у внутреннего угла глаза. Боль усиливается при пальпации. Из носа отделяются слизисто-гнойная и гнойная жидкость.
Острый верхнечелюстной синусит называется гайморит. При этом заболевании больного беспокоит головная боль, которая может отдавать в область глаз, в зубы, в скулы.
Особенно большую опасность золотистый стафилококк в носу представляют для людей со слабой сопротивляемостью организма. В таких случаях инфекция легко проникает в легкие и вызывает пневмонию.
Относительно безобидный для других людей стафилококковый ринит у больного со слабым иммунитетом способен перейти в воспаление головного мозга, сердца, почек и других жизненно важных органов. Стафилококк, переселившийся из носа на внутренние органы, способен стать причиной летального исхода.
Симптомы инфекции
Что говорят врачи о паразитах
Доктор медицинских наук, профессор Гандельман Г. Ш.:
Занимаюсь обнаружением и лечением паразитов уже много лет. С уверенностью могу сказать, что паразитами заражены практически все. Просто большинство из них крайне трудно обнаружимы. Они могут быть где угодно — в крови, кишечнике, легких, сердце, мозге. Паразиты в буквальном смысле пожирают вас изнутри, заодно отравляя организм. В итоге, появляются многочисленные проблемы со здоровьем, сокращающие жизнь на 15-25 лет.
Основная ошибка — затягивание! Чем раньше начать выводить паразитов, тем лучше. Если же говорить о лекарствах, то тут всё проблематично. На сегодняшний день существует только один действительно эффективный антипаразитный комплекс, это Toximin. Он уничтожает и выметает из организма всех известных паразитов — от головного мозга и сердца до печени и кишечника. На такое не способен больше ни один из существующих сегодня препаратов.
В рамках Федеральной программы, при подаче заявки до 12 октября. (включительно) каждый житель РФ и СНГ может получить одну упаковку Toximin БЕСПЛАТНО!
Необходимо различать носительство стафилококка и стафилококковую инфекцию. Если анализ показал, что в носу есть стафилококк, но нет реальных симптомов болезни, то для беспокойства нет повода.
В таких ситуациях не нужно глотать антибиотики или пытаться вылечить себя другими медикаментозными средствами. Оптимальным шагом будет принятие мер по укреплению иммунитета. Сильному организму стафилококк не опасен.
Наоборот, при развившейся инфекции без лечения не обойтись. Стафилококковая инфекция – состояние, при котором бактерии активизировались и стали причиной заболевания носоглотки.
Характерные симптомы стафилококковой инфекции:
- увеличение температуры тела;
- насморк, в том числе гнойный;
- общее недомогание;
- боли в зеве;
- потеря голоса;
- потеря обоняния;
- постоянная заложенность носовых ходов;
- боль в носовых пазухах;
- появление вязкой слизи в горле;
- слизистая носоглотки распухает и краснеет;
- в носу и под ноздрями появляются гнойнички;
- зуд в ноздрях.
Без лечения инфекция переходит в хронические лор-заболевания, обычно в ринит. Если патологический процесс не остановить, ринит переходит в ангину, гайморит или отит.
загрузка…
Диагностика
загрузка…
Обнаружить золотистый стафилококк в носу можно с помощью микроскопического исследования. Анализируемым материалом является отделяемое носоглотки.
Материал для исследования забирают в медучреждении. Перед сдачей анализа больной должен прекратить прием любых антибиотиков.
Медработник отбирает биоматериал стерильным валиком и помещает в пробирку. Максимум через 3 часа проба должна попасть в лабораторию, где ее перенесут на кровяной агар в чашку Петри и поместят на сутки-двое в термостат с температурой 35-37 градусов. В таких условиях в чашке Петри разрастутся колонии микроорганизмов.
Лаборант с помощью микроскопа сможет определить, являются ли эти разрастания колониями стафилококков или других, более безобидных микроорганизмов. Если в чашке Петри будет обнаружен стафилококк, специалист, скорее всего, сразу же проведет исследование на чувствительность микроорганизмов к группам антибиотиков, чтобы врач смог подобрать наиболее эффективное лечение.
В некоторых случаях для диагностики используют бактериоскопический метод, когда мазок готовят непосредственно из отделяемого носа, окрашивают по грамму и изучают в микроскоп. В таком мазке могут быть видны отдельные клетки стафилококков и их скопления в виде виноградной грозди.
Методы лечения
Стафилококковую инфекцию лечат антибиотиками и обработкой носовых ходов антисептическими препаратами. Если заболевание протекает бессимптомно, антибактериальное лечение не назначается. Пациенту рекомендуется уделить больше внимания мерам по укреплению иммунитета.
Лекарственные средства
Если воспалительные процессы в носу носят хронический или рецидивирующий характер, а бактериологический анализ показал присутствие большого количества стафилококковых клеток в отделяемом носоглотки, врач назначает антистафилококковую терапию. Ее основные принципы:
- Лечение может проводить только врач – лор, терапевт или педиатр.
- Перед назначением лекарств проводят определение резистентности бактерий к группам антибиотиков.
- Самолечение не допускается, так как стафилококковая инфекция трудно поддается обычному лечению. Для избавления от нее приходится использовать комплексную терапию.
От стафилококковой инфекции можно избавиться с помощью Амоксиклава и антибиотиков из групп трициклических гликопептидов, пенициллинов, цефалоспоринов.
ммЛечение дополняют натуральными антисептиками. Широко применяется препарат Хлорофиллипт, масляный раствор которого используют для лечения инфекций даже у маленьких детей.
Хлорофиллипт закапывают в нос по две-три капли в каждую ноздрю трижды в день или ставят турунды, пропитанные препаратом. Назначают мазь Мупироцин – бактерицидное средство широкого спектра действия, губительно действующее на стафилококки, в том числе золотистый и метиленрезистентные штаммы. Для угнетения стафилококков применяют спрей Мирамистин – антибактериальный препарат широкого спектра действия.

Штаммы, устойчивые к антибиотикам, уничтожают особыми препаратами, содержащими лизаты бактерии, то есть частички стафилококков и других микроорганизмов. Данные препараты усиливают выработку в крови антител и повышают естественную защиту организма. Лизаты к стафилококкам содержатся в препаратах: ИРС 19, Имудон, Бронхомунал.
Что можно сделать в домашних условиях?
Люди совсем недавно узнали о золотистом стафилококке, но народные целители умели справляться с инфекциями еще до изобретения антибиотиков. В некоторых природных средствах содержатся мощные антибактериальные соединения.
Например, для метиленустойчивого Staphylococcus aureus, практические неуязвимого для любого современного лекарства, крайне губительны фитонциды, содержащиеся в луке, чесноке, ягодах. Научно доказано, что Staphylococcus aureus и туберкулезные палочки погибают от фитонцидов капусты и хрена.

Во многих диких травах содержится мощный спектр природных соединений, способных справиться со стафилококками. К их числу относятся шалфей, зверобой, чистотел. Исследования показали, что природные антибиотики растенияй, не уступают по эффективности синтетическим.
Сильным антибактериальным действием обладает эфирное масло. Одно из самых эффективных в борьбе со стафилококками средств – эфир чайного дерева. Масла применяют в виде сухих и влажных ингаляций, полосканий.
Можно ли уберечься?
Наши читатели пишут
Тема: Во всех бедах виноваты паразиты!
От кого: Людмила П. ([email protected])
Кому: Администрации otparazitoff.ru
Здравствуйте! Меня зовут
Людмила Петровна, хочу высказать свою благодраность Вам и вашему сайту.
Наконец-таки я смогла вылечить сальмонеллез. Веду активный образ жизни, живу и радуюсь каждому моменту!
А вот и моя история
С 45 лет начались проблемы с кишечником и пищеварением, постоянные боли в животе, тошнота, рвота после каждого приема пищи, постоянная диарея, все было очень плохо… Один раз были такие сильные и острые боли в левом подреберье, что даже скорую пришлось вызывать. Чего только не пробовала, больницы, поликлиники, правильное питание, дорогущие лекарства… ничего не помогало.
Так я мучалась почти 15 лет! Все изменилось, когда дочка дала прочитать мне одну статью в интернете. Сначала я ужаснулась, но потом последовала совету, который там написан и не представляете на сколько я за это благодарна. Эта статья буквально вернула мне смысл жизни. Последние 2 года появилась невероятная бодрость, куча энергии, весной и летом каждый день езжу на дачу, выращиваю помидоры и продаю их на рынке. Тетки удивляются, как я все успеваю, откуда столько сил и энергии, все никак не поверят, что мне 62 года.
Кто хочет прожить долгую и энергичную жизнь со здоровой кишечником и нормальным пищеварением при любом питании, уделите 5 минут и прочитайте эту статью.
Перейти к статье>>>Уберечь себя от контакта с золотистым стафилококком невозможно, так как эта бактерия широко распространена в окружающей среде. Чтобы не допустить активизации условно-патогенных микроорганизмов, нужно вести здоровый образ жизни и своевременно уничтожать очаги инфекции во рту и в носовых ходах. Источниками стафилококка в носу могут стать кариозные полости, аденоиды и даже коньюктивит.
От стафилококковой инфекции застрахованы люди с крепким иммунитетом, соблюдающие правила личной гигиены.
При обнаружении стафилококковой инфекции у одного из членов семьи, пройти обследование должны все домашние. Скорее всего потребуется одновременное лечение всех людей, тесно контактирующих с больным. Через 3 месяца после окончания терапии делают контрольный анализ.
В видеоматериале подробная информация о стафилококке и ситуациях, когда его необходимо или не нужно лечить. На связи доктор Комаровский:
Лечение золотистого стафилококка нельзя назвать простым. Оно занимает продолжительное время и требует тщательного подхода. Врачи всего мира испытывают трудности, связанные с терапией заболеваний, вызванных этим микроорганизмом, что связано с его быстрой приспособляемостью к антибиотикам.
Стафилококк в носу — что делать (и чего делать не нужно)? Мнение Е.О. Комаровского:
В процессе лечения нужно постоянно контролировать эффективность назначаемых лекарств путем лабораторных исследований данного штамма стафилококка на чувствительность к антимикробному препарату.
загрузка…
otparazitoff.ru
Симптомы и признаки стафилококка в носу у взрослых – как он проявляется 2019
Стафилококк – это условно-патогенная бактерия, которая при снижении иммунитета может привести к целому ряду серьезных заболеваний. Пока человек здоров, стафилококк для него не опасен, и он может даже не подозревать, что является носителем этой бактерии. Но при обострении хронических заболеваний, простуде, после перенесенных травм и операций стафилококк начинает активно себя проявлять. Поэтому важно знать симптомы стафилококка в носу, чтобы вовремя выявить его и принять меры для быстрого устранения.
Содержание статьи
Факторы риска
Заразиться стафилококком может каждый. Достаточно коснуться поверхности, на которой находится бактерия, руками, а затем любого открытого участка кожи. С не меньшей легкостью она распространяется воздушно-капельным путем. Потому и избавиться от этой бактерии практически невозможно. Она является постоянным обитателем пунктов общественного питания, туалетов, больниц и детских учреждений.
Риск подхватить инфекцию значительно повышается при:
- несоблюдении элементарных гигиенических правил;
- ослабленном иммунитете;
- авитаминозе и недостаточном количестве минералов и микроэлементов;
- частых или хронических респираторных заболеваниях;
- длительном применении сосудосуживающих назальных капель;
- большом стаже табакокурения;
- необоснованном приеме антибиотиков;
- рыхлости или воспалении слизистых оболочек носа;
- царапинах, травмах и других повреждениях кожи.
Есть большая вероятность заражения при проведении медицинских процедур и манипуляций с нарушением стерильности или грязными руками. Особенно легко стафилококком заражаются дети, так как их иммунитет еще не достаточно развит, чтобы противостоять бактерии, а кожа и слизистые очень нежные и чувствительные.
Основные симптомы
Легче всего стафилококку оказаться в полости носа. Туда его можно занести немытыми руками, просто вдохнуть слюну чихнувшего или кашлянувшего рядом человека и т.д. Слизистая выстилка носовых проходов очень нежная и постоянно увлажнена, что создает практически идеальные условия для активного размножения бактерии.
Проявляется обычно стафилококк в носу следующими симптомами:
- покраснение, воспаление, иногда отечность слизистой оболочки;
- незначительное стойкое повышение температуры тела;
- повышенное выделение слизи из носа, часто гнойный насморк;
- слабость, головокружения, тошнота и другие признаки интоксикации;
- множественные мелкие гнойничковые высыпания на слизистой и коже носа.
При поражении носоглотки может достаточно быстро развиться гнойная ангина, которая даст резкое повышение температуры, боль в горле, сильный кашель. При попадании в носовые пазухи к общей картине подключается гайморит, синусит, отит.
Иногда первые симптомы стафилококка в полости носа выражены неярко и их легко пропустить. А болезнь обнаруживается лишь тогда, когда возникшие респираторные симптомы какое-то время не поддаются обычному лечению. Это может осложнить ситуацию, поскольку за это время стафилококк активно увеличивает свою численность и распространяется все дальше.
Возможные осложнения
Главная опасность состоит в том, что подселившись в организм и активно развиваясь, стафилококк не ограничивается внутренней полостью. Он распространяется дальше по слизистой, поражает носоглотку, гортань и добирается до внутренних органов. Поэтому при отсутствии лечения или применения неправильных препаратов могут возникнуть очень серьезные осложнения:
- Желудочно-кишечные расстройства. Сопровождаются жидким стулом (приводит к дисбактериозу и обезвоживанию), полным отсутствием аппетита, частой рвотой, постоянным подташниванием, нередки сильные боли в области живота.
Кожные заболевания: воспаления волосяных мешочков, дерматиты, экземы. На пораженных участках кожи появляются гнойные прыщи, фурункулы, карбункулы, причем не единично, а целыми группами.
- Пневмония. К счастью, развивается редко, чаще у малышей или ослабленных после операции или перенесенных ранее тяжелых заболеваний взрослых. Если не заметить вовремя, возможна гнойная пневмония и обструктивный синдром.
- ЛОР-заболевания. Попадание стафилококка в носовые пазухи или евстахиеву трубу может спровоцировать гнойный гайморит, фронтит, хронический ринит, отиты. Одновременно присутствует сильное воспаление и отек слизистых носа.
- Стафилококковый эндокардит. Серьезное заболевание сердца, которое может привести к очень тяжелым поражениям сердца и мозга и даже летальному исходу.
- Болезнь Риттера. Эти осложнения также чаще встречаются у детей, так как их кожа более нежная и тонкая, легко поражается бактериями. Болезнь проявляет себя появлением по телу четко очерченных красных пятен.
- Токсический шок. Возникает только у больных с сильно ослабленным иммунитетом вследствие отравления всего организма вырабатываемым стафилококком токсинами. Выглядит как очень сильное отравление: резкое повышение температуры, сильная рвота, слабость, потеря сознание, падение артериального давления.
Вылечить такие осложнения гораздо тяжелее, чем обезвредить стафилококк на ранней стадии. Ситуацию ухудшает то, что серьезные поражения внутренних органов и сильные воспалительные процессы снижают иммунитет, а это, в свою очередь, способствует дальнейшему размножению стафилококков.
Поэтому, если есть хотя бы подозрение на присутствие в организме этой бактерии, необходимо немедленно сдать анализы и начать активное лечение.
Методы диагностики
Стафилококк – это не тот диагноз, который можно поставить «на глазок». Единственным способом его обнаружить является лабораторное исследование взятой на анализ слизи из носа. Образец в стерильных условиях помещается в чистую питательную среду, где ему создаются идеальные условия для беспрепятственного размножения. Это исследование называется бактериальный посев.
Примерно через сутки образец тщательно изучается под микроскопом, и специалист может определить: тип стафилококка, скорость роста колонии, степень поражения, а также проверить данный штамм на резистентность к различным антибактериальным препаратам. На основании этого анализа врач выберет наиболее эффективный способ лечения.
К сожалению, довольно часто стафилококк в носу симптомы типичные для себя не проявляет, но все равно поражает внутренние органы и провоцирует развитие заболеваний. Выявить его в данном случае можно только случайно или тогда, когда сопутствующая болезнь долго не поддается лечению, и врач решает проверить больного на стафилококк.
В некоторых случаях выявить стафилококк помогает анализ крови, в котором могут быть обнаружены определенный вид антител. Заподозрить его присутствие можно, если общий анализ крови указывает на сильно пониженный иммунитет, а на коже и в носу периодически появляются гнойные высыпания.
Способы лечения
Основных способов лечения стафилококка два – это курс антибактериальной терапии или стафилококковый бактериофаг. Какой из них наиболее эффективен в данном случае, решать может только врач по результатам проведенного обследования. Антибиотики могут вызвать аллергическую реакцию и имеют ряд противопоказаний, зато гарантированно справляются с бактерией.
Стафилококковый бактериофаг – по сути, временная прививка против стафилококка. Он представляет собой жидкость, в которой присутствуют враждебные к бактерии микроорганизмы. Они уничтожают болезнетворные бактерии, одновременно погибая сами. К этому средству противопоказания отсутствуют. Но оно на какое-то время может усилить симптомы общей интоксикации.
Одновременно обязательно принимаются средства для укрепления иммунитета. Это могут быть растительные экстракты: эхинацеи, элеутерококка, женьшеня или специальные препараты: «Иммунал», «Иммунекс» и др. Авитаминоз может существенно замедлить процесс выздоровления, поэтому желательно одновременно пропить хороший мультивитаминный комплекс.
С внешними проявлениями стафилококка также необходимо бороться, чтобы не допустить его распространения на другие участки кожи и слизистых. К спиртовым растворам и перекиси водорода он нечувствителен. Зато с ним отлично справляется хлорофиллипт, причем как на масляной, так и на спиртовой основе.
Вторым злейшим врагом стафилококка является обычная зеленка, которой 2-3 раза в день надо смазывать пораженные участки. Она быстро подсушивает гнойнички и не дает болезни переходить дальше.
Очень важно долечиться до конца. Это значит, что предписания врача должны выполняться до тех пор, пока повторный анализ не покажет, что проблема полностью ликвидирована. Иначе оставшиеся микроорганизмы адаптируются к применявшимся препаратам и перестанут на них реагировать. И при следующем обострении бороться с ними будет намного труднее.
Профилактические меры
Никакая профилактика не даст полной гарантии того, что вы не заразитесь одним из видов стафилококка. Как уже было сказано, это бактерия очень живучая, а создать в обычной жизни условия близкие к стерильным просто нереально, да и ненужно, так как на нашей коже и слизистых обитает и множество полезных микроорганизмов.
Поэтому профилактические меры должны быть нацелены в первую очередь не на то, чтобы избежать заражения, а на то, чтобы укрепить организм и дать ему возможность самостоятельно сдерживать размножение патогенной микрофлоры. А значит – все силы надо направить на:
- Укрепление иммунитета. Конечно же, не в стадии обострения стафилококка или хронических заболеваний. Помогут в этом активный образ жизни, занятия спортом, закаливающие процедуры, контрастный душ, плавание.
- Исцеление от хронических заболеваний. Любая хроническая болезнь сильно ослабляет иммунную защиту организма, а значит – любой инфекции легче навредить организму. Поэтому не только стафилококк может спровоцировать хроническую болезнь, а и болезнь может создать условия для размножения стафилококка.
- Правильное использование бытовой химии. Сейчас многие увлекаются сильнодействующими бытовыми химикатами. Безусловно, они значительно облегчают процесс уборки помещения, но при этом убивают не только болезнетворные, но и полезные микроорганизмы, ослабляя естественную защиту кожи. Поэтому работать с ними надо в перчатках и использовать умеренно.
- Соблюдение правил гигиены. Мыть руки перед едой и после посещения туалета надо всегда, а не только в местах общественного пользования. Желательно всегда иметь при себе антибактериальные влажные салфетки или карманный флакончик с антисептиком и применять их при необходимости.
- Правильное хранение и обработка продуктов. Стафилококк с поверхности недомытых овощей и фруктов может попасть не только в желудок, но и оказаться сначала на руках, а затем в носу, ротовой полости, горле. Поэтому в жаркое время года желательно их не только мыть, но и обдавать кипятком, в котором бактерия погибает мгновенно.
Своевременное обращение к врачу. Обращаться за медицинской помощью надо, как только вы обнаружили у себя признаки, позволяющие заподозрить присутствие патогенных бактерий, а не тогда, когда вы уже попытались их полечить самостоятельно и потерпели фиаско. В крайнем случае, сразу расскажите врачу, как вы действовали, чтобы он понимал, какие из методов лечения уже будут неэффективны.
- Отказ от вредных привычек. Курение табака, злоупотребление алкоголем, применение наркосодержащих препаратов систематически отравляют организм, ослабляет иммунную систему. А курение еще разрыхляет и истончает слизистые носа, облегчая проникновение болезнетворных микроорганизмов.
Помните о том, что стафилококк в носу живет у 9 из 10 взрослых людей. Это лишь условно-патогенная бактерия, которая сильно навредить здоровому человеку просто не в состоянии. Поэтому здоровый образ жизни и крепкий иммунитет – лучшая защита от стафилококка и вызываемых ним осложнений.
Автор: Анна Александрова
Источники: medscape.com, health.harvard.edu, medicalnewstoday.com.
liergroup.ru
симптомы и лечение у взрослых
СТАТИСТИЧЕСКИЕ ДАННЫЕ
В носу у взрослого, а точнее на поверхности его слизистой оболочки, постоянно присутствует несколько безвредных разновидностей данной бактерии. Разновидностью бактерии, которая наиболее опасна для человека, является бактерия золотистого стафилококка, которая при попадании на слизистую носа начинает активный процесс размножения, отравляя организм инфицированного человека токсинами, что ведет к развитию многочисленных воспалительных процессов.
Статистика заболевания:

- Лишь 5% населения земли обладают таким иммунитетом, при котором слизистая носа полностью чиста от данных условно-патогенных бактерий.
- Число постоянных носителей данной бактерии составляет около 20%.
- 60% людей в течение жизни хотя бы однажды становились переносчиками данного условно-патогенного микроорганизма.
- Большинство носителей бактерии золотистого стафилококка являются медицинскими работниками.
- Назальная форма заболевания диагностируется у 99% новорожденных.
- Золотистый стафилококк обладает очень высокой стойкостью к воздействию окружающей среды. Бактерия не погибает под воздействием перекиси водорода, но гибнет под действием красок из анилиновой группы.
- Бактерия золотистого стафилококка провоцирует развитие более 100 опасных человеческих болезней.
ПРИЧИНЫ И СИМПТОМЫ
В носу золотистый стафилококк образуется в основном по причине резких нарушений в механизме работы защитной системы организма.
Факторы, влияющие на развитие инфекции:
- Сильные переохлаждения.
- Тяжелый период акклиматизации и недостаточная адаптация к новым условиям.
- Лечение одновременно текущих инфекционных заболеваний противомикробными препаратами, которые имеют форму капель.
- Неверный подбор антибиотических средств при лечении болезней.
Люди, которые часто используют средства, которые способствуют сужению сосудов в носу, входят в основную группу риска по золотистому стафилококку, а при постоянных нервных перенапряжениях, нарушениях психоэмоционального состояния и стрессах вероятность заражения — максимальна.
Также болезнь может начать активное развитие после попадания на слизистую оболочку носа большого количества патогенных бактерий (при контакте с больным), а также при использовании общих с инфицированным человеком вещей и средств гигиены.
Пути передачи инфекции:
- Воздушно-капельный.
- Контактно-бытовой.
- Алиментарный.
- Артифициальный.
- Воздушно-пылевой.
Симптомами золотистого стафилококка в носу чаще всего являются постоянный насморк (ринит) и затруднение процесса дыхания.
Симптомы:

- Выделение секрета в виде прозрачной слизи в начале заболевания, которая в ходе развития болезни становится гуще из-за примесей гноя.
- Резкая смена голоса – он становится гнусавым и сиплым.
- Резкий скачок температуры тела до 38, а иногда и до 39 градусов.
- Появление гнойников и покраснение кожного покрова в области вокруг носа.
- Потеря возможности ощущать запахи.
Для болезни характерно постоянное дыхание ртом, что часто приводит к бессоннице и, как следствие данного состояния, к высокой раздражительности.
Симптомы в виде специфических болезней:
- Гайморит: заложенный нос, сильный насморк, озноб, сильные зубные и головные боли, отеки век.
- Фронтит: сильная слабость и повышенная усталость, частые головокружения, непереносимые головные боли.
- Атрофия слизистых оболочек носа: чувство зуда и сильной сухости.
ЗАБОЛЕВАНИЯ, ПРОВОЦИРУЕМЫЕ ЗОЛОТИСТЫМ СТАФИЛОКОККОМ
После проявления симптомов золотистого стафилококка и его распространения по организму могут возникнуть следующие заболевания.
Из наиболее частых осложнений встречаются болезни носовой полости, такие как ринит, фарингит, гайморит и синусит.
Другие часто возникающие заболевания:
- Ларингит.
- Бронхит.
- Остеомиелит.
- Пневмония.
- Пиодермия.
- Острое пищевое отравление.
ДИАГНОСТИКА И ЛЕЧЕНИЕ
Чтобы вылечить стафилококк в носу, самодиагностики будет недостаточно. Первые симптомы заболевания – повод обратиться к соответствующему специалисту. Только лабораторные исследования могут со 100% вероятностью определить присутствие в организме человека опасных бактерий золотистого стафилококка в носу.
Методы диагностики:
- Микроскопия мазка, взятого со слизистой оболочки носа.
- Мясопептонный бульон.
- Мясопептонный агар.
- Кровяной агар.
- Соляной агар.
- БАК-посев.
- Антибиотикограмма.
Все из указанных методов выявляют наличие бактерий золотистого стафилококка в организме человека, а также помогают точно определить, к каким антибиотикам наиболее устойчивы данные бактерии.
Антибиотики, к которым бактерия проявляет резистентность:
- Тейкопланин.
- Метициллин.
- Пенициллин.
- Ванкомицин.
Вследствие того, что раньше золотистый стафилококк лечили только с помощью пенициллина, у бактерии выработался специальный фермент, расщепляющий молекулы антибиотика – пенициллиназ.
В носу у взрослых стафилококк лечат в основном с помощью антибиотических препаратов после обязательной антибиотикограммы.
Лечение:

- промывание носовых полостей антисептическими растворами;
- эритромициновые и тетрациклиновые мази для носа;
- закапывание носа масляными растворами;
- иммуномодулирующая терапия;
- хирургическое вскрытие гнойников с антисептической обработкой;
- капли с умеренной сосудосужающей функцией;
- антигистаминные средства;
- комплекс минералов и витаминов;
- антистафилококковые плазмы и иммуноглобулин;
- анатоксины.
Для лечения стафилококка в носу у беременных (которым противопоказаны антибиотические средства) используют антистафилококковый бактериофаг, который имеет широкий спектр применения (от местного до внутривенного).
Следует помнить, что данная бактерия может быть смертельно опасной для человека, поэтому любые народные методы при лечении данного заболевания недопустимы. Отсутствие своевременного и согласованного с врачом лечения может вызвать сепсис, кому и летальный исход!
ПРОФИЛАКТИКА И ПРОГНОЗ
Опасен ли золотистый стафилококк – вопрос, на который медицина давно дала положительный ответ и разработала целый комплекс профилактических мероприятий, соблюдение которых снизит риск подвергнуться данному инфекционному заболеванию практически до нуля.
Главнейшее – это соблюдение правил личной гигиены и своевременное лечение любых инфекционных и простудных заболеваний.
По мере возможности нужно избегать любых контактов с больными стафилококком, а медицинским работникам рекомендована обязательная вакцинация и строгое соблюдение правил при диагностике и лечении инфицированных.
Также следует с особой осторожностью принимать антибиотические и противомикробные средства.
Для противостояния появлению любых признаков золотистого стафилококка необходимо постоянное укрепление иммунной системы – витаминотерапия, здоровый образ жизни, занятия лечебной физкультурой.
Если хотя бы один из членов семьи подвергся заражению, все проживающие с ним должны пройти обязательную лабораторную диагностику на наличие бактерии.
Из важных профилактических мер можно выделить прием здоровой пищи и полный отказ от вредных привычек.
У взрослых симптомы заболевания в носу проходят уже через неделю после начала лечения. Если лечение сопровождать процедурами, направленными на укрепление защитной функции организма, болезнь полностью излечивается за 10-14 дней. Рецидивы встречаются редко. Работоспособность восстанавливается полностью.
Нашли ошибку? Выделите ее и нажмите Ctrl + Enter
Полезная статья Золотистый стафилококк в горлеЗолотистый стафилококк (лат. staphylococcus aureus) – это самый опасный и патогенный микроорганизм среди семейства стафилококков, способный существовать как в кислородной…
pillsman.org
причины, признаки и методика лечения у детей, взрослых и при беременности
Появление на коже лица и на слизистой носа высыпаний в виде гнойничком и шелушащихся гноящихся корочек может свидетельствовать о поражении стафилококком.
Принимать меры нужно немедленно, так как эта бактерия чрезвычайно устойчива к лечению и способна нанести организму очень большой вред. Особенно она опасна для малолетних детей и ослабленных больных, людей с дефектами иммунной системы.
Стафилококк — описание и виды

Особенности развития стафилококковой инфекции в носу
Стафилококки — это грамположительные бактерии, широко распространенные в окружающей среде. Это неоднородный вид, существует множество разных типов стафилококков, часть из них относится к условно-патогенной микрофлоре, а другие — опасные для человека и других млекопитающих патогены.
Обитают стафилококки в природе повсюду, он находятся на любом предмете, в воздухе и на коже, слизистых человека. Получается, что этот возбудитель способен поразить любого человека, для этого ему нужно лишь дождаться оптимально подходящих условий, при которых численность патогенной микрофлоры превысит защитный барьер организма. Очень часто проявляется стафилококк в носу, лечение которого должно быть очень быстрым, так как возбудитель может легко распространиться по дыхательным путям и поразить носоглотку, горло и «спуститься» во все внутренние органы.
В носу у каждого здорового человека стафилококки постоянно обитают, но далеко не всегда становятся причиной заболевания.
Эти возбудители поддаются воздействию водных растворов солей серебра и жидкостей, содержащих серебро. Особый стафилококковый бактериофаг способен бороться с этой опасной инфекцией, но есть такие формы возбудителя, с которыми не могут справиться самые сильные современные антибиотики.
Существует несколько основных видов стафилококков:
- Золотистый стафилококк — наиболее опасный, так как способен поражать любые ткани организма и вызывать серьезнейшие заболевания, в том числе и пневмонию, менингит. Название свое он получил за способность вырабатывать пигмент золотистого цвета. Некоторые формы возбудителя особенно устойчивы к антибиотикам из группы пенициллинов и цефалоспоринов, поэтому они с огромным трудом поддаются лечению и приводят к крайне опасным заболеваниям.
- Сапрофитный стафилококк чаще всего становится причиной заболеваний мочеполовых органов — цистита и уретрита.
- Эпидермальный стафилококк обитает на слизистых оболочках и человеческой коже, становится причиной появления конъюнктивита, инфицирования ран и мочеполовых органов, вызывает заражение крови и эндокардит. Таким же образом действует и гемолитический стафилококк.
Считается, что этот возбудитель в разных формах обитает на коже и слизистых оболочках около 70% населения планеты, но болезни он вызывает далеко не во всех случаях.
Должны совпасть сразу несколько причин, благодаря которым инфекция может начать активно развиваться:
- Превышение пороговой численности бактерий. Если что-то спровоцировало активный рост инфекции, она обязательно найдет слабое место в организме.
- Снижение защитных функций иммунитета.
- Наличие «открытых ворот» для проникновения бактерий. Это может быть крошечная царапина, ссадина, растертая пятка или поврежденная при неосторожном сморкании слизистая оболочка носа.
Причины возникновения

Золотистый стафилококк — самая опасная разновидность стафилококка
Стафилококки начинают атаковать организм в следующих случаях:
- При несоблюдении правил личной гигиены, чаще всего — отсутствия привычки постоянно мыть руки, особенно перед едой, после посещения туалета или возвращения с улицы. Грязное тело буквально кишит различными микроорганизмами, достаточно небольшого повреждения и заболевание обеспечено. Очень частым источником инфекции становятся деньги, ведь они бесконечно переходят из рук в руки, «собирая» на себя огромную коллекцию разнообразных возбудителей. Использование антибактериального мыла неэффективно, так как микрофлора быстро мутирует и легко привыкает к действию препаратов, а вот мытье рук с щеткой для вымывания грязи из-под ногтей, напротив, очень полезно. Оно уничтожает до 90% всей инфекции на руках.
- Контактное заражение с носителем стафилококка. Может происходить при рукопожатии, использовании чужих личных вещей им приборов, косметики. Очень часто заражение происходит в медицинских учреждениях.
- Использование антибиотиков дольше положенного срока или же без особой необходимости, а также применение антибактериальных и сосудосуживающих капель для носа длительное время.
- Снижение защитных функций иммунитета. Оно может быть вызвано различными заболеваниями, переохлаждением или перегреванием, промоканием под дождем, сильным стрессом или усталостью, пищевым отравлением и многими другими факторами.
Иногда причиной заболевания становятся сразу несколько причин. Например, человек побывал в больнице, «подцепил» там несколько лишних возбудителей, по дороге попал под холодный дождь, промок и замерз, а попав домой, не вымыл первым делом руки, а сразу схватился за бутерброд, потер глаза грязной рукой или высморкался. Итог — инфицирование и крайне неприятное, сложное в лечении и опасное для здоровья заболевание.
Признаки
Насморк, кожная сыпь и повышение температуры — признаки стафилококковой инфекции
Инфицирование обычно проявляется достаточно бурно:
- Повышается температура тела, при массированном заражении иногда до очень высоких показателей.
- Появление насморка.
- Отек слизистых оболочек носоглотки.
- Появление красных пятен в области поражения.
Гнойничковое высыпание или обильные гнойные выделения с образованием болезненных корок характерно для тех случаев, когда обнаруживается стафилококк в носу, лечение которого должно быть немедленным.
Если замешкаться с лечением, инфекция может быстро распространиться по дыхательным путям, вызывая ангины, фарингит, бронхит, воспаление легких и многие другие заболевания.
Очень часто человек, особенно маленький ребенок, расчесывает образовавшиеся в носу и на окружающей коже пустулы и ранки, разнося инфекцию по всему лицу и телу. В таких случаях лечение должно быть комплексным, так как стафилококковая инфекция, особенно при золотистой ее форме, очень коварна и устойчива к лечению. Запущенные болезни с кожных покровов и слизистых носа могут поразить весь организм, а для малыша это смертельно опасно.
Методы диагностики

Бакпосев на стафилококк
Для того, чтобы диагностировать заболевание и точно выявить имеющуюся форму стафилококка, проводится кожная проба с перенесением инфекции в чашку Петри для выращивания колонии.
Посев необходим и для того, чтобы определить, к каким антибиотикам у задействованного штамма нет резистентности. В противном случае даже массированное применение самых современных антибактериальных препаратов может не дать нужного эффекта.
Если заболевание уже развилось и имеются осложнения или подозрения на их наличие, врач может назначить дополнительные исследования, например, рентгенографию гайморовых и лобных пазух, или же тщательный осмотр слизистых носа для выявления возможных повреждений.
Медикаментозное лечение
Эффективное лечение стафилококковой инфекции в носу может назначить только врач
Когда выявляется стафилококк в носу, лечение всегда назначается индивидуально и проводится комплексно. Так как в каждом имеющемся случае проявляется «персональный» набор возбудителей, универсального лечения не существует.
В обязательном порядке врач выбирает антибиотик, наиболее эффективный против выявленного штамма бактерии, и полностью расписывает прием препарата. Отступать от схемы нельзя, так как не доведенное до конца лечение неэффективно и может сделать болезнь хронической. При первом же удобном случае стафилококк вернется и нанесет удар в спину с еще большей силой, так как ранее использованный антибиотик на него уже не будет действовать.
Кроме антибиотиков используется противостафилококковый бактериофаг, активно уничтожающий возбудителя инфекции.
Так как развитию микроорганизмов способствует падение иммунитета, необходимо использовать средства, повышающие и укрепляющие его уровень. Проводится иммунотерапия при помощи антистафилококкового анатоксина или иммуноглобулина. Местная терапия слизистой носа и ходов при помощи промывания носа раствором специальных препаратов, например, Хлорофиллипта.
Больше информации о золотистом стафилококке можно узнать из видео:
При сильном развитии гнойников и высыпаний необходимо проводить их обработку подсушивающими и противовоспалительными препаратами. Если болен ребенок, нужно ему объяснить, что корочки трогать и расчесывать нельзя. Профилактически необходимо обрезать ему ногти очень коротко и зашлифовать острые края пилочкой, чтобы он ненароком не сорвал «болячку». Если же это произошло, рану обрабатывают «зеленкой», а руки тщательно моют со щеткой.
Для противостояния болезни пациенту необходимо качественное питание с высоким содержанием витаминов, укрепляющих иммунитет, особенно витамина С. Если нет аллергии, хорошо давать чай с медом, цитрусовые, яблоки и другие свежие фрукты.
Народные рецепты

Лечение стафилококка в носу народными методами
Чтобы справиться с инфекцией, когда находится стафилококк в носу, лечение народными средствами предполагает использование отваров укрепляющих трав внутрь, промывание носа обеззараживающими средствами и применение природных иммуностимуляторов, таких, как эхинацея и женьшень.
Такое комплексное воздействие хорошо помогает на ранних стадиях незапущенных заболеваний, особенно если речь идет не о золотистом стафилококке. Также очень хорошо использовать витаминные средства природного происхождения, например, отвар шиповника, мед и другие целебные препараты, которые дает нам сама природа.
Для промывания носа или введения турунд используют отвар череды, которая хорошо справляется с гнойными сыпями.
Нужно отметить, что лечение народными средствами также должно быть комплексным, то есть включать прием препаратов внутрь и внешнее воздействие. Однако в тяжелых случаях лучше не рисковать и народными методами дополнять, а не заменять основное медикаментозное лечение.
Лечение стафилококка у детей и грудничков
У маленьких детей стафилококк в носу, лечение которого может назначить только врач, осложняется выбором препаратов, так как не все антибиотики разрешены малышам определенного возраста.
В этом случае подбор средств лечения целиком и полностью лежит только на медицинском работнике, так как родители, желая своему чаду только добра, могут нанести его здоровью серьезный вред.
При локализации стафилококка в носу у ребенка может помочь безопасный препарат Хлорофиллипт на растительной основе. Его раствором промывают нос и смазывают болезненные ранки. При необходимости врач назначит другие лекарства. Предписания необходимо точно и четко выполнять, чтобы болезнь не стала хронической или не дала осложнений.
Стафилококк при беременности
Безопасное лечение стафилококковой инфекции в носу во время беременности
У беременной лечить стафилококк труднее всего, так как антибиотики и многие другие средства использовать запрещено из-за риска навредить будущему ребенку. Однако и без лечения обойтись невозможно, так как женщина становится источником опасной инфекции, которая может поразить и плод.
В этом случае для лечения используются такие же безопасные препараты, как и для маленьких детей, например, Хлорофиллипт. Также проводится иммунизация стафилококковым анатоксином, чтобы инфекция не повлияла на развитие и здоровье будущего ребенка.
Хорошее действие оказывает применение кварцевой лампы — бактерии гибнут от облучения, а гнойные высыпания быстрее подсушиваются и заживают.
Только в исключительных случаях, когда речь идет о спасении жизни матери или ребенка или обоих сразу, врач может принять решение о применении подходящих антибиотиков и других препаратов.
Возможные последствия

При неправильном лечении стафилококковой инфекции могут возникнуть опасные осложнения
Если диагностирован стафилококк в носу, лечение проведено, но оказалось неэффективным или не было доведено до конца, то заболевание может перейти в хроническое состояние или стать причиной очень опасных осложнений. Любые формы стафилококка опасны для здоровья, но золотистый стафилококк может угрожать жизни. В его силах поразить легкие, вызвать тяжелейшую форму пневмонии, а также попасть в кровеносное русло и стать причиной заражения крови — сепсиса. Это состояние может развиваться так стремительно, что лекарства просто не успевают подействовать и больной погибает.
Корки в носу при длительном заживлении приводят к образованию рубцов на слизистой и образованию тяжей из соединительной ткани, что в дальнейшем практически гарантирует длительное течение любой простуды, особенно затяжных насморков с осложнениями гайморитом, фронтитом и другими болезненными заболеваниями. В особо тяжелых случаях может пропадать чувствительность к запахам и больной либо с трудом различает запахи, либо не ощущает их вообще.
На коже, особенно вокруг носа и губ, куда стафилококк со слизистой носа попадает чаще всего, заболевание также может оставить очень некрасивые грубые следы.
Распространение стафилококка по организму грозит поражениями всех органов, в том числе и мочеполовых. Такая инфекция может стать причиной бесплодия или самопроизвольного прерывания беременности.
Так как лечение любой формы стафилококка, особенно золотистого, очень затруднено, то заражения намного проще избежать, чем бороться с его последствиями. Большую роль играет гигиена и соответствующие навыки: регулярное мытье рук, купание после посещения опасных в плане инфицирования мест, смена одежды при возвращении с улицы. Нельзя пользоваться чужими вещами, а при снижении иммунитета из-за простуды или любого другого заболевания начать принимать нужные препараты незамедлительно, сочетая их с витаминами и веществами, поддерживающими иммунную систему. Важно не дать стафилококку шанса на развитие.
Заметили ошибку? Выделите ее и нажмите Ctrl+Enter, чтобы сообщить нам.
Поделись с друзьями! Будьте здоровы!
tvojlor.com
Симптомы, диагностика, опасность и методы лечения стафилококка в носу
Стафилококк постоянно находится в организме человека, однако некоторые разновидности этой бактерии могут быть очень патогенными, провоцировать воспалительный процесс и нагноение. Стафилококк в носу может привести к различным заболеваниям.
Эта инфекция довольно быстро распространяется на другие ткани, поэтому лечение в данном случае нужно начинать как можно раньше. Диагностикой и лечением стафилококковой инфекции в носу занимается отоларинголог.
Особенности стафилококка

Стафилококк – это неподвижная бактерия шарообразной формы
Стафилококк относится к неподвижным грамположительным бактериям. Она имеет форму шара и живет колониями, под микроскопом это выглядит как виноградная гроздь. Отсюда и название – стафилококк («зерно винограда»). Эта бактерия является условно-патогенной для организма.
В определенном количестве они постоянно находятся в организме человека: в кишечнике, ротовой полости, на коже и т.д. Однако, когда эта бактерия начинает активно размножаться, это приводит к различным воспалительным заболеваниям.
Симптомы стафилококка в носу могут быть различными, но чаще это гнойная инфекция, которую трудно упустить. Она протекает бессимптомно только на самых начальных стадиях.
Наиболее распространенными являются 3 разновидности стафилококка:
- Золотистый стафилококк. Это самый патогенный вид данной бактерии. Она может обитать на коже человека, но при попадании на слизистую часто вызывает различные заболевания. Особенностью этого вида стафилококка является то, что он очень устойчив к различным антисептическим веществам, а также антибиотикам пенициллинового ряда. Вылечить подобную инфекцию можно только с помощью сильного антибиотика. Золотистый стафилококк в больших количествах вырабатывает вещество, которое является токсичным для организма.
- Сапрофитный стафилококк. Эту бактерию можно чаще обнаружить в мочевыделительной системе, где она вызывает уретриты и циститы. Тем не менее эта разновидность стафилококка является наиболее безобидной. Она чаще вызывает заболевания у маленьких детей с несформировавшейся иммунной системой. Основные места обитания сапрофитного стафилококка – это стенка мочевого пузыря, уретра и кожа рядом с гениталиями.
- Эпидермальный стафилококк. Это условно-патогенная бактерия, которую можно часто обнаружить на эпидермисе. Она может вызывать различные заболевания только при определенных условиях. Чаще всего инфекция поражает неокрепший организм новорожденных детей. У взрослого человека иммунная система быстро справляется с возбудителем.
Стафилококковая инфекция может привести к серьезным осложнениям, поэтому очень важно вовремя ее диагностировать и начать лечение. Стафилококк вызывает заболевания только в том случае, если у человека слабая иммунная система, то есть чаще он поражает организм детей и пожилых людей.
Причины и признаки стафилококковой инфекции в носу
Ринит с примесями гноя, нарушение обоняния и температура – признаки инфекции
Заразиться стафилококковой инфекцией можно различными способами. Наиболее распространенный путь заражения – это воздушно-капельный. При общении и контакте с зараженным человеком можно легко подхватить бактерию. Большое количество стафилококка выделяется при кашле и чихании. Причем источником инфекции могут быть не только люди, но и домашние питомцы.
Стафилококк может передаваться также внутриутробно, от матери ребенку. Чаще всего заражение происходит через кровь. В некоторых случаях причиной заражения служит контактно-бытовой путь. Инфекция передается через средства личной гигиены, посуду, полотенца.
Стафилококковая инфекция довольно легко передается. Иногда достаточно прикоснуться к коже зараженного человека, чтобы заболеть. По этой причине заболевших необходимо изолировать.
Признаки стафилококковой инфекции могут долгое время отсутствовать.
Заболевший может не подозревать о том, что у него в носу живет бактерия. Однако при снижении иммунитета стафилококк начинает активно размножаться, что приводит к следующим симптомам:
- Ринит. Это основной признак инфекции, который, однако, легко спутать с ОРВИ. У человека начинается воспалительный процесс слизистой носа, что приводит к нарушению дыхания, частому чиханию, заложенности и т.д.
- Появление обильных выделений из носа. Бактериальная инфекция довольно часто сопровождается гнойными выделениями из носа. Поначалу они могут быть прозрачными, жидкими, затем загустевают и приобретают зеленоватый оттенок.
- Отек слизистой и затрудненное дыхание. Воспалительный процесс нередко приводит к тому, что слизистая носа отекает. Носовое дыхание затрудняется, человеку приходится дышать ртом.
- Изменение голоса. У больного меняется тембр голоса, он становится более хриплым, гнусавым. После выздоровления голос нормализуется.
- Усталость, недомогание. Отек носа и обильное выделение слизи приводят к нарушению вкусовых рецепторов. Человек не может нормально есть, спать, отдыхать, что и провоцирует хроническую усталость.
- Гипертермия. Бактериальная инфекция чаще всего сопровождается повышенной температурой тела. Она может достигать 38-39 градусов и держаться долгое время.
Интенсивность проявления симптомов может быть различной в зависимости от состояния иммунной системы человека.
Осложнения и опасные симптомы
Запущенная стафилококковая инфекция может стать причиной гайморита или фронтита
Основная опасность инфекции в носу заключается в том, что она может быстро распространяться на другие ткани и органы. Стафилококк при создании благоприятных условий начинает довольно быстро размножаться. Наиболее опасным последствием является попадание инфекции в кровь, когда она быстро разносится по всему организму, поражает легкие, сердце, печень и другие органы.
Часто человек не подразумевает, что у него стафилококковая инфекция. Он воспринимает симптомы как банальный ринит, поэтому не идет к врачу. Однако через некоторое время заболевание осложняется, появляются симптомы ангины, бронхита, трахеита и т.д.
Стафилококковая инфекция в носу может привести к следующим осложнениям:
- Гайморит. Если бактерия проникает в гайморовы пазухи, начинается бактериальный гайморит, который приводит к сильным головным болям, повышенной температура тела, сильному отеку слизистой, который не снимается даже сосудосуживающими каплями, а также гнойным выделениям из носа. Такой гайморит довольно быстро переходит в хроническую форму при отсутствии лечения.
- Отит. Отит является частым осложнением респираторных заболеваний. Отит, вызванный стафилококком, сопровождается гнойными выделениями из уха, сильными болями, повышением температуры тела до 40 градусов, нарушением слуха. При своевременном лечении неприятных последствий можно избежать.
- Ангина. Ангина, которая вызвана стафилококком, имеет свои особенности. Как правило, миндалины заметно увеличиваются, на них со временем появляется гнойный налет или локальные гнойнички, которые сразу заметны при осмотре. Также могут появляться признаки интоксикации: повышенная температура, тошнота, рвота.
- Сепсис. В тяжелых случаях стафилококк приводит к септическому поражению крови. Это одно из самых опасных последствий инфекции. Острая форма заболевания протекает стремительно. У больного резко ухудшается самочувствие, повышается температура тела, появляется озноб, обморочное состояние, нарушение сознания. При отсутствии лечения больной погибает.
Наиболее опасной эта инфекция является для пожилых людей и маленьких детей. При сниженном иммунитете, ослабленном организме бактерия быстро размножается, вызывая обширные поражения органов, тканей, костей.
Также стафилококк представляет серьезную опасность для беременных женщин. Попадание инфекции к плоду может привести к внутриутробной гибели, преждевременным родам, выкидышам.
Диагностика и медикаментозное лечение

При подозрении на наличие стафилококка нужно сдать мазок из носа
При появлении признаков стафилококковой инфекции в носу необходимо обратиться к отоларингологу. Он осмотрит слизистую носа, а также назначит анализы. В первую очередь при подозрении на бактериальную инфекцию назначается бакпосев.
Для этого небольшое количество слизи берется для лабораторного исследования. Материал помещается в питательную среду, где бактерии начинают размножаться. Через некоторое время можно будет идентифицировать возбудителя. Анализ готовится в течение недели. Преимуществом этого метода исследования является то, что одновременно проводится анализ чувствительности бактерии к различным антибиотикам.
Дополнительно назначается анализ крови для определения признаков инфекции, определения ее распространения в организме.
Лечение должен назначать врач после постановки точного диагноза. Конечно, основным элементом терапии остаются антибиотики. Без них остановить распространение инфекции невозможно.
Лечение стафилококковой инфекции может включать в себя следующие составляющие:
- Антибиотики. Если стафилококк не золотистый, могут назначаться препараты пенициллинового ряда. Чаще всего рекомендуют Кларитромицин, Азитромицин, Амоксиклав. Препараты подбираются индивидуально с учетом возраста, состояния пациента. Дозировку также должен определять лечащий врач. Очень важно при лечении стафилококка пропить курс антибиотиков до конца. Если курс прерван, бактерия снова начнет размножаться и приобретет иммунитет к используемым антибиотикам.
- Антистафилококковый иммуноглобулин. Если антибиотикотерапия не помогает, назначается антистафилококковый иммуноглобулин. Он выпускается в виде порошка и получается из донорской крови. В препарате содержатся антитела к бактерии. Однако эффект заканчивается тогда, когда заканчивается прием препарата.
- Иммуномодуляторы. Для борьбы с инфекцией необходимо укрепить иммунную систему, активизировать ее. Чтобы повысить сопротивляемость организма, назначают Тактивин, Полудан.
Препараты можно дополнять местными средствами, например, промывать нос Мирамистином, Аквалором, Аква Марисом, использовать антибактериальные спреи.
Народные методы и советы

Промывать нос можно как медикаментозными, так и народными средствами
Народная медицина предлагает немало рецептов для борьбы со стафилококковой инфекцией. Однако нужно помнить, что не всегда этих средств достаточно. Золотистый стафилококк крайне патогенная бактерия, уничтожить которую можно только сильными препаратами. Врачи могут порекомендовать народные методы лечения в дополнение к медикаментозное терапии, однако отказываться от прописанных препаратов опасно.
При использовании народных средств нужно помнить о возможности аллергической реакции. Все рецепты лучше проверять заранее, принимая небольшими дозами и по очереди. В случае возникновения аллергии, можно будет определить, на что именно появилась реакции.
Самыми распространенными народными средствами лечения стафилококка являются:
- Черная смородина. Эта ягода содержит большое количество витамина С и других полезных веществ. По сути это естественный антибиотик, который помогает побороть инфекцию. При стафилококке ягоды можно просто есть, заварить чай, делать морсы и компоты. Также черная смородина усиливает действие принимаемых антибиотиков.
- Прополис. Прополис обладает выраженным антибактериальным эффектом. Слабым раствором настойки прополиса можно промывать нос, полоскать горло, а также его принимают внутрь, растворяя в теплом молоке.
- Фитотерапия. Справиться с инфекцией помогут эвкалипт, подорожник, шиповник, черника, череда, душица, береза. Травы можно сочетать или принимать по отдельности. Не нужно злоупотреблять травами. Одного стакана в день будет достаточно.
- Петрушка и сельдерей. Это прекрасные природные антисептики, которые можно использовать для лечения стафилококковой инфекции. Свежие петрушку и сельдерей мелко рубят, а затем отжимают сок. Этот сок можно принимать внутрь и по несколько капель закапывать в носовые ходы.
- Листья грецкого ореха. Из листьев готовят отвар и используют для полоскания горла или промывания носа. Листья грецкого ореха содержат йод, который уничтожает возбудителей заболевания.
Нужно проявлять осторожность при лечении стафилококка во время беременности. Не все средства и травы безопасны для плода. Также при лечении маленьких детей нужно избегать большого количества трав, ягод, меда, так как все это сильные аллергены.
Как можно избежать инфекции?

Соблюдение правил гигиены и поддерживание иммунитета – лучшая профилактика стафилококка
Чтобы избежать заражения стафилококковой инфекцией, в первую очередь необходимо ограничить контакты с зараженным человеком. Если дома кто-то заболел, его необходимо изолировать от других членов семьи, использовать защитные маски, проветривать помещение.
Лечение стафилококка может быть достаточно тяжелым и длительным, так как он быстро размножается и приводит к неприятным последствиям, если иммунитет ослаблен.
Чтобы предотвратить заражение и появление осложнений, нужно придерживаться некоторых правил профилактики:
- Своевременная диагностика. Источником инфекции может стать даже маленький очаг. Поэтому не стоит откладывать визит к врачу. Необходимо своевременно лечить кариес, грипп, ОРВИ и прочие инфекции.
- Соблюдение правил личной гигиены. После посещения улицы необходимо мыть руки с мылом. У каждого члена семьи должно быть свое полотенце, зубная щетка, бритвенный станок и т.д.
- Укрепление иммунитета. Чтобы организм мог побороть инфекцию, необходимо принимать поливитаминные комплексы, правильно питаться, закаляться, больше гулять на свежем воздухе, заниматься спортом, отказаться от вредных привычек.
- Избежание переохлаждения. Частое переохлаждение, вдыхание холодного воздуха, привычка ходить в зимнее время без шапки приводят к различным заболеваниям, в том числе и к стафилококковым инфекциям.
- Правильный отдых. Люди, которые погружаются с головой в работу, постоянно пребывают в стрессах, сильно устают, гораздо более подвержены различным инфекционным заболеваниям. Необходимо давать организму отдых, чтобы он копил силы для борьбы с различными инфекциями. Не менее важен и правильный полноценный сон.
Подробнее о стафилококковой инфекции в носу можно узнать из видео:
Если у одного из членов семьи обнаруживается стафилококк, сдать анализы должны все. Это довольно заразное заболевание, поэтому лучше перестраховаться. У кого-то стафилококк может присутствовать в скрытой форме, то есть он будет носителем заболевания.
Заметили ошибку? Выделите ее и нажмите Ctrl+Enter, чтобы сообщить нам.
Поделись с друзьями! Будьте здоровы!
tvojlor.com
причины, симптомы и лечение у взрослых, фото
Стафилококк представляет собой патогенную бактерию, которая может провоцировать развитие воспалительно-гнойных патологий. В настоящее время современной медициной классифицировано более 20-ти разновидностей этого патогенного микроорганизма. Большинство видов является постоянными спутниками человека и в минимальном количестве присутствуют на слизистых, не вызывая при этом никаких заболеваний.
Особенности

Золотистый стафилококк в носу очень опасен. У здорового человека этого микроба (фото можно посмотреть выше) не должно присутствовать в организме. Если бактерия попадает в носоглотку, то начинает активно размножаться. Патогенный стафилококк в процессе жизнедеятельности выделяет токсины, которые провоцируют интоксикацию и развитие воспалений. В области носоглотки также может вести подрывную деятельность стафилококк эпидермальный и гемолитический.
Стафилококк ауреус, согласно данным статистики, которая ведется многими медицинскими учреждениями из разных стран мира, присутствует почти у 20% населения планеты, взрослых возрастных групп. Из этого количества приблизительно у 60% людей стафилококк aureus периодически локализируется в носу и горле. Только у 5% носителей слизистые носоглотки не заселены патогенными бактериями благодаря тому, что местный иммунитет хорошо выполняет свои функции.
Симптоматика

Многие люди даже не подозревают, что у них в носу присутствует патогенная микрофлора. Такую категорию больных современная медицина классифицирует как носителей.
У них признаки стафилококка проявляются при наличии благоприятных для бактерии факторов:
- происходит снижение общего либо местного иммунитета;
- случается обострение хронических патологий;
- произошло переохлаждение;
- произошло механическое повреждение слизистых носа и т. д.
В таких случаях патогенный микроорганизм начинает активно размножаться. У некоторых пациентов бактерия сразу после проникновения в носоглотку начинает себя проявлять и провоцирует развитие воспалений.

Такие патологические состояние сопровождают следующие симптомы:
- Появляется ринит (насморк).
- Начинает увеличиваться количество сопле, которые изначально имеют прозрачную структуру, но спустя короткий промежуток времени в слизистом секрете можно выявлять гнойные вкрапления.
- Пациентам становится сложно дышать, по причине закупорки соплями носовых проходов.
- Со стороны обоняния наблюдаются нарушения. Больным сложно или вовсе невозможно различать запахи.
- Голос становится гнусавым и сиплым.
- Больные часто дышат ртом, что иногда приводит к осложнениям. Например, развиваются воспаления бронхов, трахеи, гортани.
- У многих пациентов повышается температура. В том случае если у них развилась острая форма ринита, то температура может подниматься до 38 градусов. Если патология сопровождается осложнениями, то температура может повышаться до 39-40 градусов.
- Наблюдается нарушение сна, пациенты испытывают сложности с засыпанием.
- У больных появляется недомогание, усталость.
- Очень часто стафилококковая инфекция проникает в носовые придаточные пазухи. В таких случаях у людей может наблюдаться развитие фронтита либо гайморита.
- У юной аудитории пациентов на кожных покровах появляются высыпания.

Пути передачи

Золотистый микроб, также как и стафилококк эпидермис, поражает своих жертв незаметно.
Именно поэтому люди должны знать все пути передачи этого патогенного микроорганизма:
Воздушно-капельным | Чтобы заразиться, человеку достаточно вдохнуть воздух, в котором присутствует микроб. В окружающую среду патогенные бактерии попадают от носителей, во время разговора, кашля или чихания. Люди должны знать, что переносчиками золотистого микроба могут быть и домашние питомцы |
Воздушно-пылевым | После того как носители микробов выделяют их в окружающую среду, они оседают на микрочастичках пыли. Здоровый человек заражается при вдохе, так как вместе с воздухом проникает и пыль с микробами |
Контактный (бактерия передается во время внутриутробного развития, во время прохождения через родовые пути, во время грудного вскармливания) | Таким способом инфицируются младенцы. В большинстве случаев они заражаются от своих матерей. |
Контактно-бытовой | Взрослые люди и малыши могут заразиться при использовании общих бытовых предметов, средств личной гигиены. Также золотистый микроб может проникнуть в организм своей жертвы при поцелуе, при прикосновении к кожным покровам |
Инфицирование в общественных местах | Как правило, золотистая бактерия всегда присутствует в помещениях с большим скоплением людей. Также заражение может произойти и в условиях стационара |

На причины возникновения стафилококковой инфекции могут повлиять сопутствующие патологии и факторы:
- Перенесенный стресс. Длительное нахождение человека в состоянии депрессии. Сильнейшие нервные потрясения и срывы.
- Переход хронических патологий в острую фазу. В данном случае идет речь о таких заболеваниях: о фарингите, аденоидите, тонзиллите.
- Одним из основных факторов, провоцирующих развитие воспалений в носу, является переохлаждение. Например, человек находится на улице в морозное время года. Он вдыхает носом холодный воздух, в результате чего реснички, отвечающие за процесс очистки полостей, начинают очень активно двигаться. Патогенные микроорганизмы, которые проникают в нос вместе с воздухом, оседают на слизистых и начинают активно размножаться.
- Возрастная группа пациента. Согласно статистике, которая ведется медицинскими учреждениями, существуют возрастные категории людей, которые более подвержены инфекционным патологиям. Например, маленькие дети, пенсионеры.
- Состояние здоровья. Как правило, люди, которые имеют заболевания, протекающие в хронической форме, входят в группу риска приобрести стафилококковую инфекцию.
- Грипп и ОРВИ. Очень часто эти патологии приводят к развитию стафилококкового ринита. Это происходит из-за снижения местного и общего иммунитета. В результате патогенный микроорганизм пробуждается именно в пик развития заболевания.
- Восприимчивость организма. Некоторые больные вынуждены на протяжении длительного промежутка времени принимать различные медикаменты. В результате у них повышается восприимчивость организма к патогенной микрофлоре.
- Длительное применение капель от насморка, обладающих сосудорасширяющим воздействием. У такой категории пациентов может развиваться лекарственный ринит. В результате для стафилококковых бактерий образуется благоприятная среда.
Опасность

Если патогенный микроб поселяется в носу, то у взрослых, либо у малышей могут возникнуть следующие осложнения:
- Воспаление развивается очень стремительно. Если своевременно не удастся купировать этот процесс, то он распространится сразу на дыхательные пути, а потом и на рядом расположенные органы. Используя лимфатический либо гематогенный путь, микроб может добраться до сердца, печенки и т. д.
- У многих людей изначально развивается ринит. Через время к нему присоединяются различные заболевания, например аденоидит, гайморит, ангина, отиты и т. д. У пациентов, которые имеют определенную предрасположенность, патогенный микроб может спровоцировать развитие трахеита, бронхита.
- У людей преклонного возраста и у малышей помимо вышеперечисленных заболеваний могут развиваться более тяжелые патологии: поражение сердца, почек, печенки, головного мозга, костей, развиваются абсцессы.
Диагностические мероприятия
Чтобы обнаружить золотистый микроб специалисты должны провести обследование больного и только после этого назначить лечение. В обязательном порядке берется мазок из зева и носа, который передается в лабораторию на исследование. Может проводиться быстрый анализ, для которого задействуется микроскопическая методика. Но он не позволяет определить вид бактерии.

Также проводится тест на чувствительность патогенной микрофлоры к тем или иным видам антибиотиков. После того, как по результатам проведенных лабораторных исследований было выявлено в биологическом материале наличие стафилококков, в количестве, превышающем 106 ед., больному назначается медикаментозный курс терапии.
Методы лечения

Специалисты предпочитают лечить стафилококковые инфекции посредством антибиотиков. Для каждого пациента индивидуально разрабатывается схема, так как врачи учитывают возрастную категорию, тяжесть течения патологии и другие сопутствующие факторы.
В том случае, когда золотистый микроб был обнаружен в носу, больным прописываются следующие медикаментозные препараты:
- Таблетки «Флемоклава», «Амоксиклава».
- Таблетки «Цефалотина», «Цефалексина», «Азитромицина», «Эритромицина», «Ванкомицина».
- В том случае, когда назначенные антибиотики не смогли справиться со стафилококковой инфекцией, специалисты проводят корректирование медикаментозных схем. При наличии опасности развития серьезных осложнений пациентам прописывается лекарство «Анатоксин», либо иммуноглобулин антистафилакокковый. Благодаря этим медикаментам удастся купировать процесс развития интоксикации. Также специалисты могут прописать больным бактериофаги антистафилакокковые.
Чтобы вылечить стафилококковую инфекцию можно задействовать следующим медикаменты, которые прописывают врачи такой категории больных:
Группа иммуномодуляторов | Таблетки «Иммунорикса», «Полудана», «Тактивина» | Способны повышать сопротивляемость организма патогенной микрофлоре |
Группа антиаллергенных медикаментов | Таблетки «Диазолина», «Тавегила», «Зиртека» | Прописываются больным для снятия отеков |
Группа витаминно-минеральных комплексов | Таблетки «Супрадина», «Алфавита» | Назначаются для полноценной работы организма, восполнения утраченных в ходе болезни сил |
Специалисты прописывают пациентам лекарственные средства для наружной обработки слизистых:
- Группа антисептиков, в которую целесообразно включение «Хлоргексидина», «Мирамистина». Люди должны приобрести эти медикаменты в аптечных сетях в виде раствора. Его следует задействовать для промывания носа.
- Группа антибактериальных лекарственных средств. В нее целесообразно включение «Изофра», «Полидекса», «Протаргола». Они продаются в аптечных сетях в капельной форме, оказывают помимо антибактериального эффекта, сосудосуживающее воздействие.
- Если у пациента вокруг носа образовались гнойниковые высыпания, то врачи назначают мази для наружной обработки, например, «Тетрациклиновую», «Эритромициновую». В этих кремообразных субстанциях присутствует антибиотик.
- Показано при стафилококковой инфекции в носу применять местно иммуномодуляторы, например, «Иммудон».
- Больным рекомендуется проводить промывание носовых пазух посредством препарата «Хлорфиллипт». Также они могут задействовать капли, в составе которых присутствуют аналогичные компоненты.
- Если на кожных покровах, в области носа, появились крупные гнойниковые образования, то для их вскрытия следует обратиться в медицинское учреждение.

Профилактика
Несмотря на то, что ни один человек не застрахован от проникновения в его организм золотистой бактерии, можно попытаться минимизировать риск заражения:
- Следует избегать мест с большим скоплением людей, особенно если у кого-то из присутствующих наблюдается насморк, либо респираторное заболевание.
- Необходимо избегать переохлаждения.
- Каждый человек должен несколько раз в год проводить витаминотерапию.
- Крайне важно следить за состояние иммунитета.
- Необходимо регулярно соблюдать личную гигиену.
- Если контактирование с больным человеком неизбежно, то нужно соблюдать все меры предосторожности.
- После посещения улицы и мест общего пользования следует мыть руки.
- Не следует при выявлении золотистой бактерии заниматься самолечением. В этом случае не сможет избавиться от микробов, а напротив, они могут проникнуть в кровоток.
yachist.ru